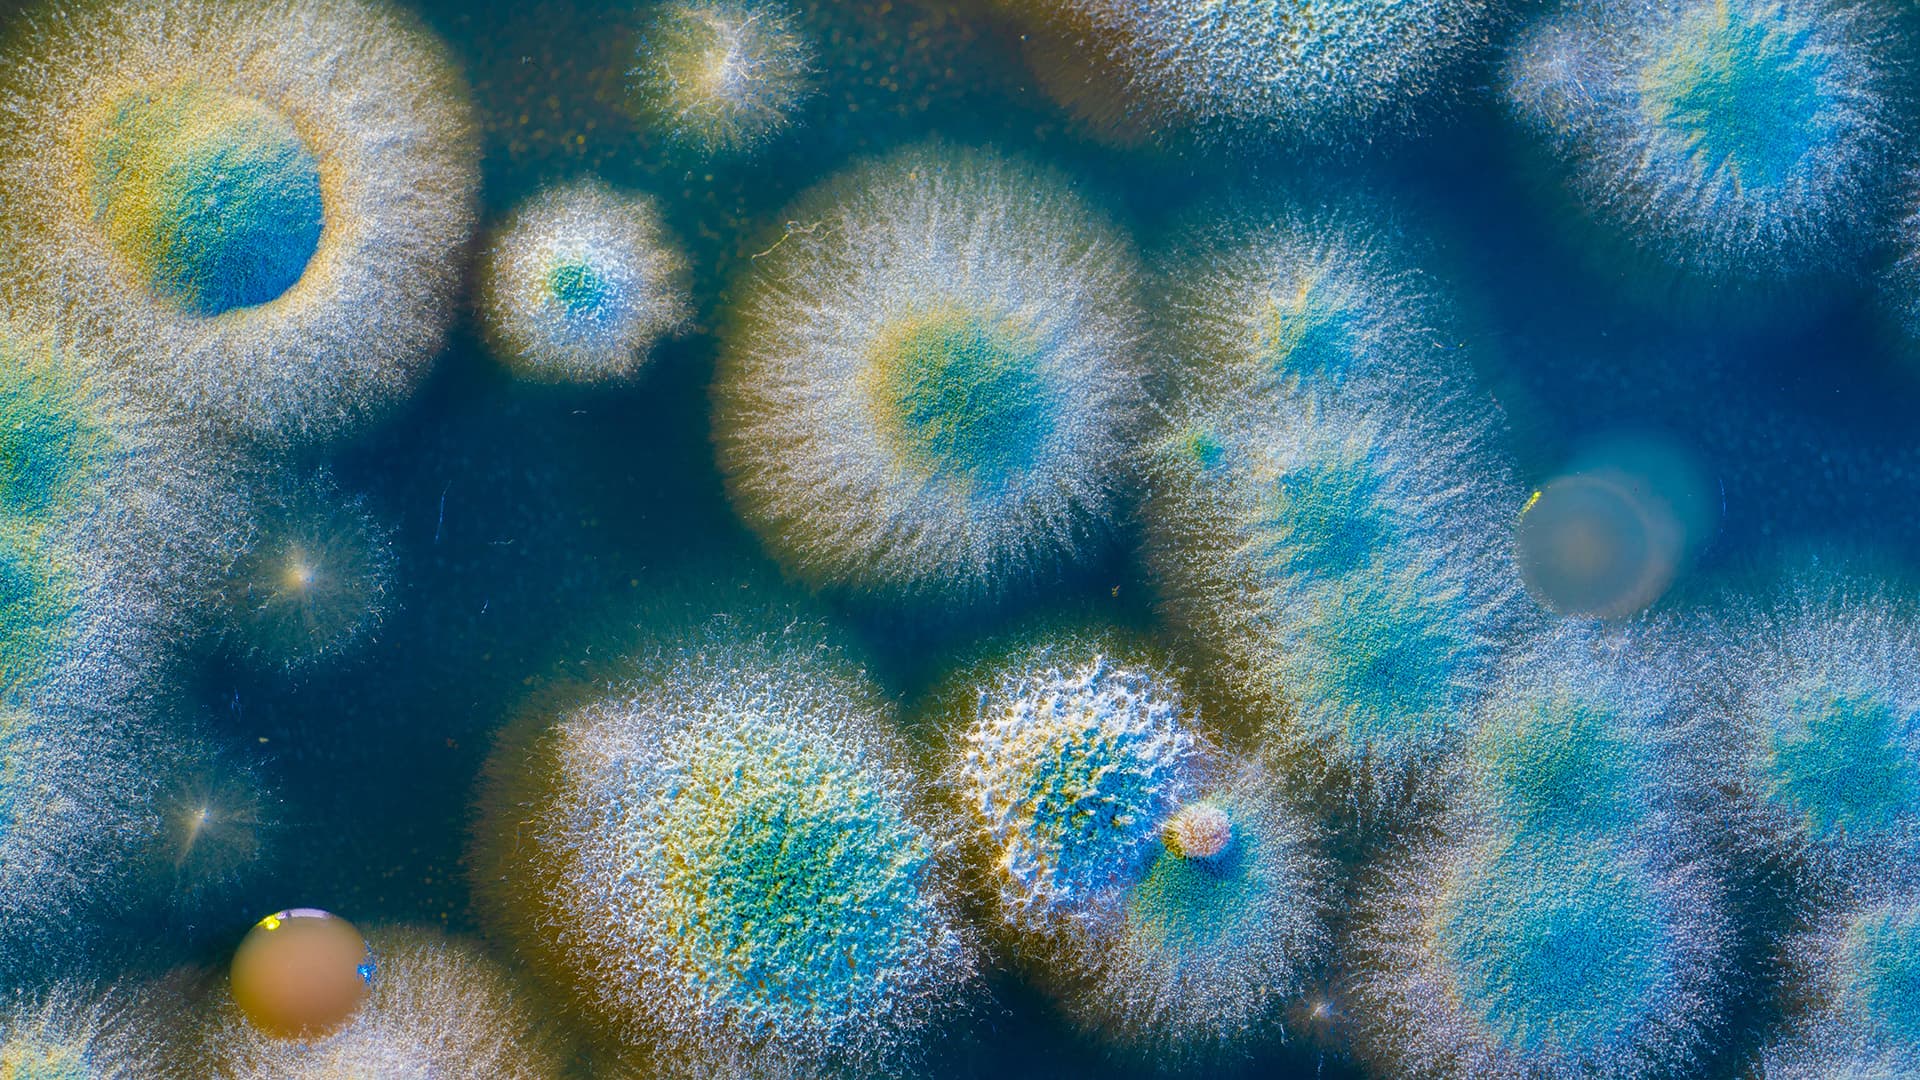

.jpg&w=3840&q=75)
As the world moves past the pandemic, Ginkgo Biosecurity is looking toward the future as well, considering new frameworks for countering biological threats.
The future of infectious disease surveillance, along with planning and preparing for the next biological threats and emerging risks, must expand beyond an exclusively public health lens. Although biosecurity—the application of modern biotechnological tools, at scale, to counter biological threats of all origins—certainly is a matter of consequence for public health, biosecurity is also inextricably linked to national security. We now understand the ways pandemics can disrupt our political systems, economies, and the global movement of people and goods, as well as feed misinformation cycles and in general negatively impact society, all of which can be considered national security issues, as well as public health concerns. Decision makers should broaden the scope through which new infrastructure to counter biological threats is designed and funded.
According to the U.S. Department of Defense (DoD)’s recent Biodefense Posture Review report, developing resilience to “biothreats and biological hazards (biohazards) provides the first step to deter the use of bioweapons and deliberate attack.” The report suggests that robust, ongoing biosecurity investment will make biological attacks seem less appealing to malicious actors because such attacks would likely be detected quickly and neutralized effectively.
Effective biosecurity will demand developing a national security framework for tracking and detecting biological risks, including ongoing funding and prioritization for the deterrence of and response to threats that do arise—an issue that has plagued public health initiatives for pandemic preparedness in the past and which should be addressed now.
Expanding Beyond the Public Health Lens
Biosecurity is more than just pandemic prevention. A comprehensive approach includes the ability to detect and respond to engineered, offensive biological threats. According to the Biodefense Posture Review, “The United States assesses that North Korea and Russia maintain offensive biological weapons programs … and identifies concerns with Iran’s activities.”
Because of the very real risk of biological attacks from malicious actors, a robust biosecurity approach must inherently straddle the line between the worlds of public health and national security. The same biosecurity structures that countries would use to detect and respond to natural pathogens must also be capable of detecting and countering malicious, engineered biological threats.
Leaving biological threat preparedness solely to the realm of public health agencies alone could also result in biosecurity vulnerabilities. Public health authorities and guidance have become politicized over the course of the pandemic, and this is unlikely to change. Another approach could offer an opportunity for a paradigm shift. The Center for Strategic and International Studies (CSIS) argues in a recent paper that “a stark legacy of the pandemic is partisan polarization around many key policies and interventions, especially pertaining to vaccines, masks, and the approach to schools and businesses during an emergency.” Because of this polarization, the authors argue, trust and confidence in science and public health institutions has declined within the general public. However, there could be an opportunity for the political narrative around biological threats to shift, if biosecurity is treated as an essential component of national defense.
A paradigm shift in framing biosecurity as a national security priority could also ensure that key infrastructure that was developed during the pandemic does not become underfunded, and does not become a victim of what CSIS and the World Bank have called “the predictable cycle of crisis followed by complacency and neglect.” Decision-makers are reluctant to put significant funding towards preparing for future events that might not come to pass, such as epidemics and pandemics. Biosecurity is likely to enjoy more regularly appropriated funding as part of the national defense portfolio.
The Way Forward
Ginkgo Biosecurity is building the kind of global bioradar that is now essential to national security. It collects and processes threat information on a global scale to empower national security and public health decision making. Supported by Ginkgo’s AI-enabled threat models and predictive capacity to identify where the next biological risks are emerging, governments can feel confident in the biosecurity component of their national defense. The global awareness that this bioradar can provide is vital because biology doesn’t respect borders.
National security organizations must embrace biosecurity as a priority. An ongoing and robust biosecurity capability should include detection, analysis, and rapid response mechanisms; given the rising risk posed by infectious disease, these have the potential to be among the most important components of national defense.